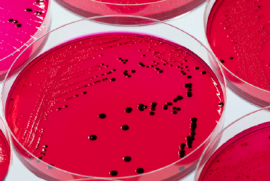

USDA внедряет новые правила для борьбы с сальмонеллой
Департамент сельского хозяйства (USDA) ужесточил правила борьбы с сальмонеллой (salmonella). Отныне все изготовители птицы и яиц будут обязаны отслеживать опасную бактерию в течение всего производственного процесса. Один факт заражения может привести к большим штрафам, долгосрочным проверкам и закрытию бизнеса.
Глава USDA Том Вилсак рассказал, что решение о «нулевой терпимости к сальмонелле» было принято после экстренного совещания с Центром по контролю и профилактике заболеваний (CDC). По итогам прошлого года, CDC зафиксировал 1.35 млн. заражений сальмонеллой. По крайней мере 125 тысяч человек заболели после употребления в пищу куриного мяса и 43 тысячи - после мяса индюшек.
Сальмонелла - одно из самых тяжёлых заболеваний, которое лечится только с помощью антибиотиков. Болезнь сопровождается плохо контролируемой диареей. Заболевшие, как правило, не могут выйти из дома в течение 4-6 дней. Переболевшие сальмонеллой часто подают иски на продавцов некачественных товаров и требуют компенсации за пережитые страдания.
Новые правила мониторинга сальмонеллы на производстве копируют правила мониторинга E. coli (продукты жизнедеятельности животных), введённые CDC и USDA ещё в 1994 году. Тогда количество случаев заражения E. coli удалось снизить на 50%. В частности, коровьи фекалии перестали попадать в фарш, который ещё 30 лет назад считался одним из самых опасных мясных продуктов.
Самый простой способ минимизировать вероятность заражения сальмонеллой - доводить продукты (мясо птицы, яйца) до полной готовности. Вместе с тем USDA и CDC по-прежнему не рекомендуют мыть курицу, индейку и яйца в раковине. Причина - опасные бактерии могут осесть на поверхности раковины, а потом перебраться на кухонную посуду.
Вадим Дымарский






.jpg)















